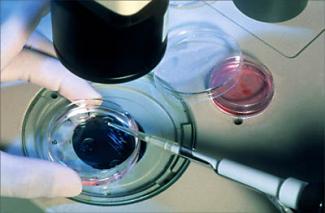

Istanbul, Turecko, 4. júl 2012 (LifeSiteNews.com) – Od narodenia prvého “bábätka zo skúmavky“ na svete, Louise Brownovej, uplynulo 34 rokov. Zatiaľ čo niektorí lekári oslavujú odhadovaných 5 miliónov žijúcich ľudí splodených prostredníctvom technológií asistovanej reprodukcie (ART, vrátane IVF a ICSC), prominentný kritik túto technológiu odsudzuje pre neetické zaobchádzanie s ľudským životom. Tiež tvrdí, že ide len o imaginárne riešenie pre ženy trpiace neplodnosťou.
Dr. Thomas W. Hilgers vo svojom vyhlásení pre LifeSiteNews uvádza: „Ak 5 miliónov detí bolo narodených v dôsledku oplodnenia in vitro, potom najmenej 6-krát toľko životov bolo potratených v najskoršej a najzraniteľnejšej fáze vývoja v maternici.“
Dr. Hilgers, seniorský konzultant v pôrodníctve, gynekológii, reprodukčnej medicíne a chirurgii na Inštitúte pápeža Pavla VI. a profesor na katedre pôrodníctva a gynekológie na fakulte medicíny Creightonskej univerzity sa odvolával na fakt, že pri typickom IVF postupe je vytvorených oveľa viac embryí, než bude nakoniec implantovaných do maternice matky. Ostatné sú buď zmrazené na dobu neurčitú, alebo jednoducho zničené.
Odhadovaný počet žijúcich ľudí stvorených prostredníctvom ART bol prezentovaný na 28. výročnom stretnutí Európskej spoločnosti pre ľudskú reprodukciu a embryológiu (ESHRE), ktorý sa konal prednedávnom v tureckom Istanbule.
Aktuálne údaje ukazujú, že každoročne je globálne realizovaných okolo 1,5 milióna ART cyklov, výsledkom ktorých je asi 350 000 bábätiek. Tieto čísla dokazujú, že 1,15 miliónov zákrokov nie je účinných, čo predstavuje obrovskú stratu na rodiacich sa ľudských životoch. Najaktívnejšou krajinou v ART zákrokoch je Amerika, za ňou nasleduje Japonsko.
Komentujúc to, čo ESHRE nazýva “významný medzník“, Dr. David Adamson, predseda Medzinárodného výboru pre sledovanie technológií asistovanej reprodukcie (ICMART) povedal, že technológia ART sa „v priebehu rokov výrazne zlepšila a zvýšila počet tehotenstiev“.
„Bábätká sú rovnako zdravé ako bábätká tých neplodných pacientov, ktorí počali spontánne“, uviedol.
Avšak, výskumy publikované v posledných rokoch naznačujú čosi iné.
Nedávna štúdia s názvom “Meta-analýza: Vrodené chyby u detí počatých oplodnením in vitro a intracytoplazmatickou injekciou spermie“ vedie k záveru, že deti počaté technológiou ART, či už ICSI alebo IVF majú “významne zvýšené riziko vrodených vád“ v porovnaní s deťmi počatými prirodzene/spontánne.
Prepojenie medzi ART a vrodenými vadami, prípadne inými zdravotnými problémami je natoľko významné, že v roku 2009 britský vládny úrad pre výskum embryí varoval potenciálnych rodičov, že u detí počatých umelým oplodnením in vitro existuje o 30 % vyššie riziko genetických porúch.
Podporovatelia tejto technológie sa však takýmito zisteniami nedajú odradiť.
„Päť miliónov bábätiek je jasným dôkazom, že IVF a ICSI sú nevyhnutnou súčasťou normalizovaných a štandardizovaných klinických terapií na liečbu neplodných párov“, povedala Dr. Anna Veiga, predsedkyňa ESHRE a riaditeľka pre vedu na Inštitúte Dexeus univerzity v Barcelone. Dodala, že „od začiatkov IVF sa veľa zmenilo, zvlášť výsledky v termínoch narodení bábätiek, ale stále je čo zlepšovať“.
Dr. Simon Fishel, výkonný riaditeľ CARE Fertility, VB a člen skupiny Edwards a Steptoe v Cambridge, zodpovedný za narodenie Louise Brownovej uviedol, že „5 miliónový míľnik ... ospravedlňuje všetky právne a morálne boje, etické diskusie a ťažko vybojovaný sociálny súhlas“, s ktorými je ART spojený.
„Pri hranici piatich miliónov bábätiek, a toto číslo stále rastie, môžeme, podľa môjho názoru pokojne povedať, že veľká väčšina problémov týkajúcich sa plodnosti či už u mužov, alebo žien môže byť úspešne a bezpečne vyliečená prostredníctvom IVF alebo ICSI.“, uviedol profesor André Van Steirteghem, priekopník ICSI.
Avšak, Dr. Hilgers, autor NaProTechnology, prirodzeného prístupu k starostlivosti o ženskú plodnosť, ktorá nezahŕňa abortívne alebo inak eticky otázne metódy, uviedol pre LifeSiteNews, že v Amerike ART „poslúžil len polovici 1 percenta neplodných žien trpiacich nespočetnými poruchami reprodukčného zdravia“. Zároveň dodal, že riešenia asistovanej reprodukcie „ženu nijakým spôsobom neliečia, ani nezmierňujú jej chorobu“.
NaProTechnology (Natural Procreative Technology), založená na 30-ročnom výskume plodných cyklov žien, monitoruje výskyt rôznych hormonálnych štádií počas ženského menštruačného cyklu. Metóda funguje na spolupráci ženského plodného a gynekologického systému.
NaProTechnology je údajne 1,5 – 3-krát úspešnejšia ako IVF. A to bez obrovských finančných nákladov a negatívnych emocionálnych a iných psychologických následkov, ktoré sú spojené s oplodnením in vitro.
„NaProTechnology je nielen efektívnejšia pri snahách o otehotnenie, ale taktiež sa snaží prísť na koreň problému. Chorobu chceme vyliečiť, nie len dočasne potlačiť príznaky“, povedal Dr. Hilgers. „Pre tých, ktorých zaujíma etická stránka týchto umelých technológií, mám dobrú správu: Existuje alternatívne riešenie.“